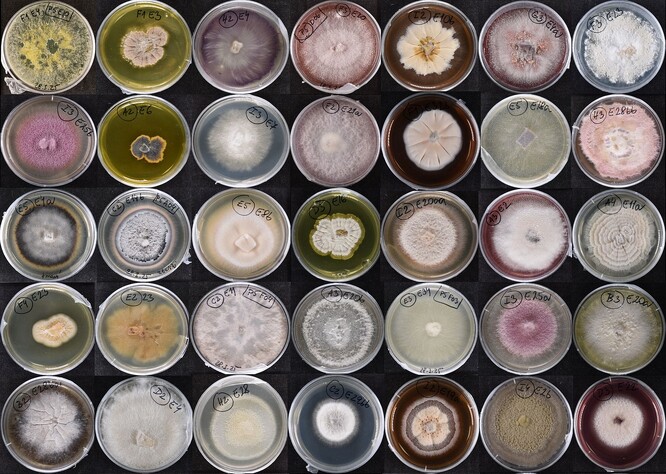
Mikroskopické houby izolované z kořenů rostlin v přírodě a kultivované na miskách v laboratoři.

Češi a Korejci budou spolupracovat na získávání důležitých látek z rostlin pomocí umělé inteligence
Rostliny mohou být zdrojem látek, které se využívají například v medicíně, kosmetice i dalších odvětvích. Umělá inteligence v novém projektu umožní zpracovat data z experimentů a rozpoznat v nich vzory, které odhalí nejvhodnější mikroorganismy pro konkrétní plodiny, sdělil Jan Bartoš, vedoucí Centra strukturní a funkční genomiky rostlin v Olomouci, které spadá pod ÚEB AV ČR.
"Hledání symbiotických mikroorganismů vhodných pro komerční pěstování plodin je náročný proces," řekl Bartoš. Zahrnuje podle něj jejich izolování z přírody, kultivaci a charakterizaci v laboratoři, sledování vlivu na rostliny za různých podmínek a určení molekulárních mechanismů zodpovědných za příznivé účinky symbiózy. "Experiment tak přináší různorodá data, ve kterých můžeme díky umělé inteligenci rozpoznat vzory a objevit mikroorganismy s největším potenciálem," řekl.
Díky spolupráci s kolegy z Koreje chtějí vědci najít prospěšné mikroorganismy, které zvýší užitek rostlin bez zátěže pro životní prostředí. "Spojení našich znalostí a zkušeností vytváří jedinečnou příležitost posunout tento výzkum kupředu," sdělil Martinec.
reklama

 Za rozvojem stromů během evoluce stojí schopnost přežít sucho
Za rozvojem stromů během evoluce stojí schopnost přežít sucho Vědci: Tělíska pomáhají rostlinám rozmnožovat se i při vysokých teplotách
Vědci: Tělíska pomáhají rostlinám rozmnožovat se i při vysokých teplotách V botanické zahradě v Liberci už 70. rokem kvete viktorie královská
V botanické zahradě v Liberci už 70. rokem kvete viktorie královská